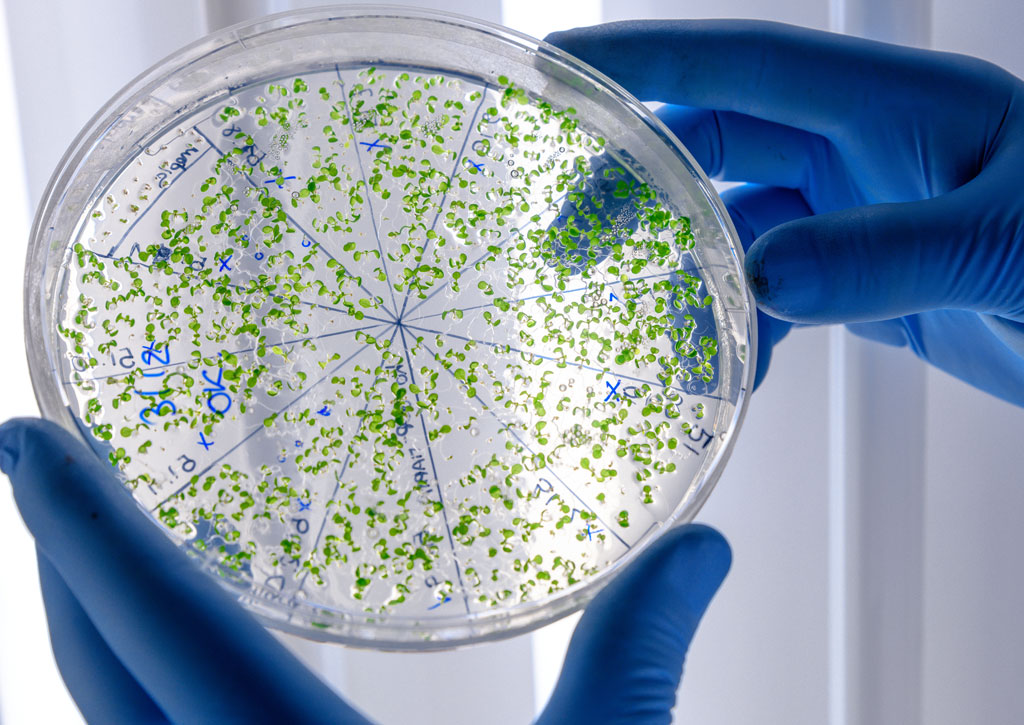

Odor Control Solutions
 Implement our control techniques to neutralize foul odors
Implement our control techniques to neutralize foul odors
Bacteria Elimination
Designed to eradicate bacteria, our solution ensures nets are safe and hygienic for continued use
Designed to eradicate bacteria, our solution ensures nets are safe and hygienic for continued use
Effective Residue Removal
 Our treatment thoroughly cleans nets, removing all traces of residues that can harm marine ecosystems.
Our treatment thoroughly cleans nets, removing all traces of residues that can harm marine ecosystems.

Invasive Species Control
Prevents the spread of invasive species, safeguarding native marine life and habitats. Our eco-friendly treatment is designed to significantly extend the lifespan of your fishing equipment. By effectively removing residues, bacterias, and invasive species without the use of harsh chemicals, our solution not only protects your gear but also reduces your overall operational costs. This innovative approach helps prevent the spread of marine diseases, ensuring a healthier marine environment.
Discover the Eco-Friendly Solution for Your Fishing Nets
Enhance your fishing operations with our innovative treatment that cleans nets effectively while safeguarding the marine environment. Connect with us today to learn how our solutions can extend the lifespan of your equipment and reduce costs.
